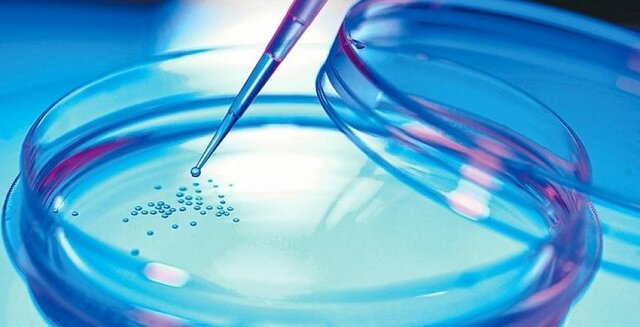
Avances Científicos

-
 -Escáner de retina portátil.
-Escáner de retina portátil.
-Radar que puede ver a través de las paredes.
-Sistema de reconocimiento facial en 3D.
-La compacta de 20 mega pixeles.
-Vehículos inteligentes con internet y deferentes contenidos digitales. -
 Cada día el hombre esta evolucionando y trae consigo la llegada de los exoesqueletos eleg, vehículos inteligentes, el descubrimiento de nuevos planetas e incluso trata de buscar tratamiento para una cura efectiva y esto para que, para un mejor crecimiento en la sociedad y un mejor desarrollo para una vida duradera.
Cada día el hombre esta evolucionando y trae consigo la llegada de los exoesqueletos eleg, vehículos inteligentes, el descubrimiento de nuevos planetas e incluso trata de buscar tratamiento para una cura efectiva y esto para que, para un mejor crecimiento en la sociedad y un mejor desarrollo para una vida duradera. -
 -Aparece, por fin, el bosón de Higgs.
-Aparece, por fin, el bosón de Higgs.
-El genoma del denisovano, secuenciado.
-Obtienen óvulos de células madre.
-El complejo aterrizaje del Curiosity.
-Rayos X contra la enfermedad del sueño.
-Ingeniería genética más precisa.
-Exóticos fermiones dan la cara.
-El ADN se queda sin basura.
-El poder de la mente.
-La clave de los neutrinos. -
 -Calentamiento global.
-Calentamiento global.
-Tejidos cerebrales transparentes.
-Implantes electrónicos biodegradables.
-Cura para el alcoholismo.
-Nacen los primeros bebes transgénicos del mundo.
-El genoma humano más antiguo tiene 400.000 años.
China llegó a la Luna. -
 La llegada de nuevos avances tecnológicos trae consigo oportunidades negativas y positivas ya que el hombre cada día intenta facilitar la manera en como vivimos diariamente, por esta misma razón trajimos consigo el calentamiento global que afecta a nivel general a los seres vivos.
La llegada de nuevos avances tecnológicos trae consigo oportunidades negativas y positivas ya que el hombre cada día intenta facilitar la manera en como vivimos diariamente, por esta misma razón trajimos consigo el calentamiento global que afecta a nivel general a los seres vivos. -
 -Tower Infinity.
-Tower Infinity.
-Gravitylight.
-Gafas Argus II.
-darpa atlas.
-Energía solar ultra-eficiente.
-Relojes inteligentes.
-Robots inteligentes más accesibles.
-Impresión 3D. -

- Drones agrícolas -Baterías para 20 años
- Auge de la impresión 3D -Blackphone. -Tecnología de exoesqueletos.
- Las fusiones nucleares.
- El monopatín aerodeslizador o ‘skater Hoverboard. -Mangalyaan y Marte. -Realidad virtual.
-
 Los inventos tecnológicos han avanzado mucho a lo largo del tiempo que ya que cada día tratan de evolucionar junto a la ciencia y junto a las necesidades del ser humano por lo tanto esto trae consigo grados ventajas y desventajas a la sociedad ya que se esta volviendo una sociedad corrompida con la manera en que el mismo hombre progresa con la tecnología avanzada, ya que se le da mal uso.
Los inventos tecnológicos han avanzado mucho a lo largo del tiempo que ya que cada día tratan de evolucionar junto a la ciencia y junto a las necesidades del ser humano por lo tanto esto trae consigo grados ventajas y desventajas a la sociedad ya que se esta volviendo una sociedad corrompida con la manera en que el mismo hombre progresa con la tecnología avanzada, ya que se le da mal uso. -
-La crisis del ébola
-La crisis del ébola
-Células madre sintéticas
- Ingeniería inversa de la naturaleza
-Controlar genes con la mente
-Reescribir los recuerdos
-Chips que imitan al cerebro
-Cultivo de células productoras de insulina.
-Detección del cáncer
-Rosetta aterriza en un cometa -
 -Vehículos de pila de combustible.
-Vehículos de pila de combustible.
-Genoma digital.
-Robótica de última generación.
-Plásticos termoestables reciclables.
-Técnicas de ingeniería genética más precisas.
-Fabricación distribuida.
-Inteligencia artificial emergente.
-La tecnología neuromórfica.
-Fabricación aditiva. -
 -La llegada a Plutón.
-La llegada a Plutón.
-La lucha contra el cambio climático.
-Secretos de las columnas del manto terrestre.
-El agua y la atmósfera de Marte.
- Nueva especie humana.
-En busca de las ondas gravitacionales.
-CRISPR, la revolución genética.
-Vacuna contra el ébola
-Levadura modificada para obtener opiáceos. -
 Como una ráfaga, el mundo ha cambiado en las últimas décadas de manera impactante. Las nuevas tecnologías nos permiten la comunicación instantánea, un acceso inusitado a la información, la simplificación de muchas tareas que antes nos llevaban muchísimo esfuerzo, la posibilidad de vivir más y mejor. Sobre esta realidad y estos favores no existen reparos sino más bien elogios y aprovechamientos.
Como una ráfaga, el mundo ha cambiado en las últimas décadas de manera impactante. Las nuevas tecnologías nos permiten la comunicación instantánea, un acceso inusitado a la información, la simplificación de muchas tareas que antes nos llevaban muchísimo esfuerzo, la posibilidad de vivir más y mejor. Sobre esta realidad y estos favores no existen reparos sino más bien elogios y aprovechamientos. -

- Nanosensores e Internet de Nanothings.
- Baterías de próxima generación.
- Blockchain.
- Materiales 2D.
- Vehículos autónomos.
- Órganos en chip.
- Células solares “Perovskite”
- Apertura de los Ecosistemas de Inteligencia Artificial (AI)
-
- Ondas gravitacionales.
- Proxima b
- Primera prueba en humanos de Crispr.
- El vertebrado mas antiguo de la tierra.
- Convertir emisiones de carbono en piedra.
-
 Actualmente, la evolución exponencial de los avances tecnológicos en entornos globales, se encuentra generando disrupción y cambios de paradigma continuos. Estos cambios se ven reflejados en las empresas y sus formas de elaborar el producto, ya que, ha subido la taza de desempleo, debido a la gran revolución de los robots y maquinas que están usando etas empresas reemplazando el trabo humano, por la razón de que les sale más económico.
Actualmente, la evolución exponencial de los avances tecnológicos en entornos globales, se encuentra generando disrupción y cambios de paradigma continuos. Estos cambios se ven reflejados en las empresas y sus formas de elaborar el producto, ya que, ha subido la taza de desempleo, debido a la gran revolución de los robots y maquinas que están usando etas empresas reemplazando el trabo humano, por la razón de que les sale más económico. -

- El retrato completo de una colisión estelar.
- Una nueva especie de gran simio.
- Fotografiar la vida a escala atómica.
- El despegue de los 'preprints' en biología.
- Edición de una letra del ADN y el ARN.
- Nueva inmunoterapia contra el cáncer.
-

- El imparable internet de las cosas.
- La tecnología 5G.
- Los nuevos materiales, como el grafeno.
- Los avances en impresión 3D.
- La inteligencia artificial.
- La robótica.
-
 La observación del entorno que nos rodea ha sido una constante en la condición humana y, como resultado de esta observación, se han alcanzado conclusiones que han permitido estructurar un amplio campo de conocimientos del mundo físico, y de nuestra cultura. La evolución de la imaginación humana para razonar y entender su entorno, y el análisis de la gestación del conocimiento técnico y científico, nos permite conocer nuestro pasado intelectual e indagar en nuestra propia evolución.
La observación del entorno que nos rodea ha sido una constante en la condición humana y, como resultado de esta observación, se han alcanzado conclusiones que han permitido estructurar un amplio campo de conocimientos del mundo físico, y de nuestra cultura. La evolución de la imaginación humana para razonar y entender su entorno, y el análisis de la gestación del conocimiento técnico y científico, nos permite conocer nuestro pasado intelectual e indagar en nuestra propia evolución. -
 El impacto a sido una serie de cambios científico-tecnológicos hicieron posible un uso potenciado de los recursos naturales. También permitió la producción en masa de productos manufacturados. Esto significó el cambio de una economía agraria y artesanal a una dominada por la industria.
El impacto a sido una serie de cambios científico-tecnológicos hicieron posible un uso potenciado de los recursos naturales. También permitió la producción en masa de productos manufacturados. Esto significó el cambio de una economía agraria y artesanal a una dominada por la industria. -
 -edición del genoma
-edición del genoma
-single cell RNA-seq
-Google AlphaGo Zero
-Óvulos de laboratorio
- escudo térmico
-La «cafetera» que detecta neutrinos
-Nueva lupa molecular -
 -Coches automatizados
-Coches automatizados
-Sticker electrónico
-Impresión de metales 3D
-Embriones artificiales
-Ciudades sensitivas
-Redes neuronales combativas
-Traducción inmediata
-Salto cuántico de materiales -
 -Supremacía cuántica
-Supremacía cuántica
-El primer sensor portátil pH para la piel
-Explican el origen de los organismos multicelulares
- Suplementos contra el hambre -
 -Autos trepadores y voladores
-Autos trepadores y voladores
-Cine en unas gafas
- La destreza de los robots
- Energía nuclear de la nueva ola
- Televisor enrollable -
 Tantos en el sistema de la salud, como en la creación de vehículos con mayor capacidad y mejoramiento con énfasis en la reducción de CO2 que ha estado afectado a los cambios climáticos que hoy en día tenemos. Por otro lado, la ciencia ha logrado dar unas excelentes noticias y el tratamiento del cáncer que afecta a una gran población del mundo y es el causante de muchas muertes. Esta noticia ha sido recibida con muchas expectativas para el mejoramiento de la vida diaria.
Tantos en el sistema de la salud, como en la creación de vehículos con mayor capacidad y mejoramiento con énfasis en la reducción de CO2 que ha estado afectado a los cambios climáticos que hoy en día tenemos. Por otro lado, la ciencia ha logrado dar unas excelentes noticias y el tratamiento del cáncer que afecta a una gran población del mundo y es el causante de muchas muertes. Esta noticia ha sido recibida con muchas expectativas para el mejoramiento de la vida diaria. -
 Cabe recalcar que hubo uno de mayor impacto.
Cabe recalcar que hubo uno de mayor impacto.
En ningún otro año de nuestra historia reciente ha estado la actualidad global tan dominada a todos los niveles por un único denominador común: en este 2020, la pandemia del coronavirus SARS-CoV-2 de la COVID-19 ha eclipsado todo lo demás. Y siendo un asunto en el que la ciencia tiene tanto que aportar, la crisis global ha acaparado los esfuerzos de la investigación científica para liberar todo el poder del ingenio humano. -

- Vacunas contra la pandemia
- Las tijeras genéticas
- En la defensa de la diversidad
- Pronósticos más precisos para el calentamiento global
- Las misteriosas ondas de radio espaciales
- La pintura más antigua jamás conocida
- Inteligencia artificial para entender una proteína
- Los “controladores de elite” para el VIH
- Superconductividad a temperatura ambiente
-

- 5G
- WiFi 6
- Analítica avanzada de datos
- Inteligencia Artificial (IA) y Machine Learning
- Blockchain
- IA Conversacional
- ACPC
- Drones autónomos, vehículos autónomos y Smart 9. Cities
- RPA
- XaaS, UX / CX y privacidad
-

- Predicción de la estructura de las proteínas mediante IA
- Aplicación de la tecnología Crispr in vivo
- La carrera por prevenir el Cóvid-19
- Misiones Espaciales
- Actividad sísmica en Marte
- 6 exoplanetas
- El asteroide más rápido del sistema solar
-

- Asistentes digitales con voz, la nueva compañía:
- Inteligencia Artificial (IA), el año de su madurez en los negocios
- Automatización de procesos Robóticos (RPA), como una realidad
- Seguridad de datos o ciberseguridad
- La migración a la multi-nube
- Analítica y minería de datos como el foco en muchas profesiones
- Realidad Virtual y Realidad Aumentada (RA)
- Comercio en línea dentro de las preferencias más altas
- Llegada de la red 5G, una red a toda velocidad
-
 Para este años los impactos hubo un avance a favor de la biodiversidad, lo cual es algo positivo y a favor. Aunque muchos de estos avances están relacionados con la creación de nuevos artefactos para la investigación y mejora de lo que actualmente existe. Pero sin dejará un lado que siempre le ocasionado un impacto negativo a nuestro planeta, con la extracción de sus minerales y la contaminación generada con algunos avances.
Para este años los impactos hubo un avance a favor de la biodiversidad, lo cual es algo positivo y a favor. Aunque muchos de estos avances están relacionados con la creación de nuevos artefactos para la investigación y mejora de lo que actualmente existe. Pero sin dejará un lado que siempre le ocasionado un impacto negativo a nuestro planeta, con la extracción de sus minerales y la contaminación generada con algunos avances. -
 -Cápsulas de tiempo de cristal de la corteza terrestre
-Cápsulas de tiempo de cristal de la corteza terrestre
- Descubrimiento del mayor reptil marino
- Edición de genes para la salud del corazón
- Cómo suenan los agujeros negros
- Detector de cáncer basado en la luz
- Agua helada volcánica en la Luna -

- Potencia informática
- Dispositivos más inteligentes
- Computación Cuántica
- Dataficación
- Inteligencia artificial y aprendizaje automático
- Realidad aumentada
- Confianza digital
- Impresión 3D
- Genómica
- Nuevas soluciones energéticas
-
 Predecir el futuro es complicado y arriesgado. En la industria de la tecnología es todavía más difícil. Las tendencias de la tecnología en 2022 vienen pisando fuerte. En los últimos años la industria ha innovado y ha sufrido varias transformaciones. Algunos de estos cambios no han sido prácticos ni rentables. Otros se han adelantado a su tiempo y otros simplemente no han tenido éxito en el mercado.
Predecir el futuro es complicado y arriesgado. En la industria de la tecnología es todavía más difícil. Las tendencias de la tecnología en 2022 vienen pisando fuerte. En los últimos años la industria ha innovado y ha sufrido varias transformaciones. Algunos de estos cambios no han sido prácticos ni rentables. Otros se han adelantado a su tiempo y otros simplemente no han tenido éxito en el mercado.
Want to make a timeline like this?
Use Timetoast to turn dates, events, milestones, and phases into a clear visual timeline you can build and share. Timetoast is a timeline maker for work, school, research, and stories.
